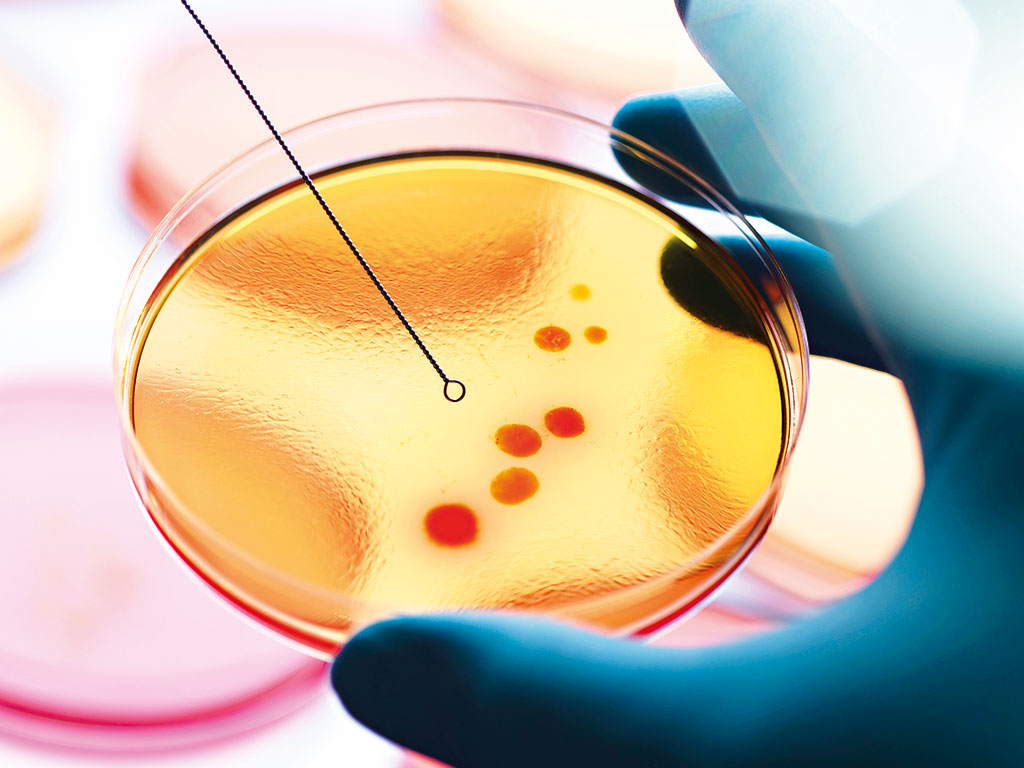

Demography is destiny, as the saying goes. One area where this undeniably true is the healthcare and pharmaceutical industry. As a result of growing populations in the developing world, and the increasingly ageing populations of North America and Europe, this sector will see continued growth, globally. In North America alone, the average growth in the sector is expected to be 4.9 percent from 2014-18. Western Europe will see 2.4 percent growth, while the Middle East and Africa could see an annual average increase of 8.7 percent, and Asia and Australasia will see an expansion of over eight percent.
As a result of this growth, the industry is seeing a boom in innovation, with biotechnology becoming increasingly important, alongside personalised treatments. Another area of growth is in rare and orphan disease treatments; a sector of the market that has previously been ignored, but has, in the last few years, become increasingly important. Defined as those that affect less than five in 10,000 of the general population, rare diseases are, as the name suggests, rare. For this reason, many drug companies have favoured research into more common ailments. This, however, is changing.
The spearhead of innovation is research into biotechnology, which is the real frontier of scientific excellence and the practical response to increasingly specific, still unmet medical needs
One firm that has committed to research into rare diseases is Italy’s Dompé Group. Founded in Milan in 1940 by the Dompé family, Dompé Group is now one of the leading biopharmaceutical companies in Italy, dedicated to the development of innovative therapeutic solutions for rare and orphan diseases. European CEO spoke to Eugenio Aringhieri, CEO of Dompé Group, about his company and what it is doing to both raise awareness around rare diseases and develop treatments for them, as well as more general trends in the booming pharmaceutical and healthcare industry.
What important changes have occurred in the sector of late?
The pharmaceutical industry has changed considerably in recent years. Up to now, the goal was to develop drugs that could offer a therapeutic response to widespread health needs, using research conducted within companies. Today’s science is more directed towards personalised treatment, with the aim of responding in a targeted manner to the needs of the individual through network-orientated research. In a scenario where the problems of health, system sustainability and a progressively ageing population have contributed to the rise of significant new challenges, those working in the healthcare sector, including businesses, must be able to deliver increasingly effective, timely and sustainable answers to those challenges.
The spearhead of innovation is research into biotechnology, which is the real frontier of scientific excellence and the practical response to increasingly specific, still unmet medical needs. Biotech is the driving force behind a virtuous cycle that combines the expertise of the research and business worlds, for the benefit of patients.
Why have targeted therapies grown increasingly popular in recent years?
Yearly, scientific research continues to make better progress. Treatments are perfected and developed for diseases previously thought to be incurable. The role of science is to provide targeted responses to specific health needs. Targeted therapies have profoundly changed the therapeutic approach in many areas, including oncology, metabolic diseases and ophthalmology. Drugs are tailored for the patient, with a clear impact on both diagnosis and disease treatment.
Today, biotechnology is one of the symbols of excellence that the pharmaceutical industry needs to pursue. Biotech drugs and vaccines are now the main response to unmet health needs. It is both a scientific challenge and a challenge to the system. In future, it will be important to promote a stable environment and equal access to innovation for the protection of patients’ right to health.
How exactly does Dompé fit into the Italian pharmaceutical and healthcare market?
Dompé has an internationalisation strategy that sees 2015 as a crucial year. Focus and core competencies are the two terms that have guided and will continue to guide our strategic choices. We have chosen our playing field in a rapidly evolving industry: research to meet patients’ unsatisfied medical needs, relying on expertise and demonstrating innovation at every level, from research and development to production. Our approach encompasses process and organisational innovation, as well as the ability to attract new resources and skills in order to achieve a real change in business culture, in line with the challenges presented by the international environment. The experience of our group is part of a tradition of excellence in the Italian pharmaceutical sector, which combines local awareness with the necessary readiness to confront global healthcare challenges.
Can you explain Dompé’s commitment to rare and orphan diseases?
On the scientific front, our efforts are concentrated on high-demand areas of healthcare, for which therapeutic responses are still insufficient, such as diabetes, ophthalmology, oncology and transplantation. We’re currently promoting more than 20 clinical trials, conducted internationally through a network of around 200 centres of excellence. Among the programmes in the most advanced stage of development are the REPARO trial, which has completed phase two, evaluating innovative solutions for patients with neurotrophic keratitis – a rare disease of the cornea with no cure to date; the fRida trial – the largest trial ever undertaken for triple negative breast cancer; and an international phase-three clinical trial to improve the results of pancreatic islet transplantation.
A commitment of this kind must necessarily involve a series of initiatives aimed at increasing awareness of orphan diseases, which are often overlooked. For this reason, we launched ‘The Rarest Ones’, a campaign designed to turn the spotlight on rare disease patients by leveraging the potential of the internet as a way to virally spread the message. The video, released on our YouTube channel on Rare Disease Day in February 2015, was designed to draw the public’s attention to a subject that is too often ignored.
What are your plans and ambitions for the future?
Our aim, in the medium and long term, is to make new therapeutic solutions for rare and orphan diseases globally available. Particularly in the medium term, Dompé aims to promote a network of excellence in biotech R&D, through highly specialised centres in three continents (Europe, North America and Asia). We also expect to increase our international presence with the opening of four new offices in rapid succession (following on from our offices in New York and Tirana, these will be in Paris, London, Berlin and Barcelona). In the long term, Dompé aims to consolidate its position as a fully-devoted, R&D-driven biotech company that is globally recognised in the field of rare and orphan diseases.
In our industry, there are no simple answers to complex problems. The scenario has changed and will continue to change in the coming years. There are three concepts that serve as a valuable compass in unknown territory: the drive for excellence, the ability to network and the skill of knowing how to select the right companions.

